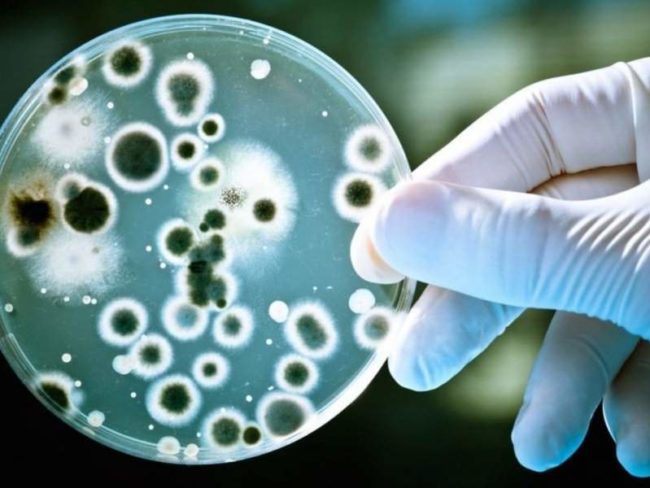

Открыты бактерии, влияющие на развитие рака легких
Открыты бактерии, влияющие на развитие рака легких Открытые специалистами микробы манипулируют работой гамма-дельта Т-клеток. Необычные бактерии, которые оказались способны влиять на иммунную систему так, чтобы ускоренно развивался рак легких, были открыты учеными из Массачусетского технологического института (США). Это выяснилось во время экспериментов на генетически модифицированных мышах, склонных к заболеванию раком. У части грызунов легкие и…